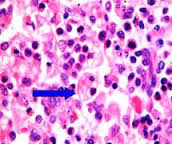
Linfohistiocitosis hemofagocítica.jpeg

Linfohistiocitosis hemofagocítica
| ||||||||
Linfohistiocitosis hemofagocítica. Es un trastorno raro que afecta más comúnmente a los bebes y los niños y que resulta de la activación exagerada de ciertas células blancas de la sangre.
Sumario
Generalidades
Descripción
La linfohistiocitosis hemofagocítica es una enfermedad rara y de pronóstico grave, que afecta principalmente a niños.
Etiología
La causa exacta se desconoce, aunque existen formas hereditarias en las que se han identificado mutaciones en el cromosoma 10q21-22, donde está localizado el gen que codifica la perforina.
Fisiopatología
Se caracteriza por proliferación incontrolada de linfocitos T activados y macrófagos que segregan gran cantidad de linfoquinas, produciéndose el fenómeno de hemofagocitosis las células que proliferan no son malignas, es decir la enfermedad no tiene relación alguna con el cáncer. Los órganos afectados son principalmente la médula ósea, hígado bazo y sistema nervioso central.
Cuadro clínico
La enfermedad se inicia generalmente durante los primeros meses o años de vida y en ocasiones, en el útero, aunque puede iniciarse también en la infancia tardía o en el adulto. Los hallados más comunes son:
- Alteraciones neurológicas: Presentes en aproximadamente 75% de los pacientes. Pueden presentar inicialmente o pueden aparecer más tarde y pueden incluir aumento de la presión intracraneal, irritabilidad, rigidez del cuello, hipotonía (disminución del tono muscular), hipertonía (aumento del tono muscular), convulsiones, parálisis de los nervios craneales, dificultad para coordinar los movimientos, parálisis de un lado del cuerpo, parálisis completa (tetraplejia), nistagmos, ceguera y coma. Los síntomas neurológicos también son una característica común de recaída de la enfermedad.
- Fiebre
- Agrandamiento del bazo y el hígado
- Recuentos bajos de células sanguíneas (causados por la destrucción de las células de la sangre por histiocitos).
Las manchas en la piel (eritema) pueden aparecer y desaparecer en asociación con fiebre alta y puede aparecer como parches de piel roja que son planos y/o elevados y firmes, o puntos planos de color rojo a púrpura. Los síntomas respiratorios varían en gravedad desde una simple tos leve hasta un síndrome de sufrimiento respiratorio agudo.
Las personas afectadas pueden tener más predisposición para desenvolver cáncer en el sangre como leucemia o linfoma.
Clasificación
Existen dos formas de la enfermedad:
- la forma primaria, que es hereditaria según un patrón autosómico recesivo y suele presentarse durante la infancia, desencadenada por la presencia de una infección por virus.
- la forma secundaria, los síntomas pueden aparecer a cualquier edad, afectando principalmente a personas que presentan deficiencias en la inmunidad, trastornos autoinmunes o cáncer, en muchas ocasiones el factor desencadenante es una infección por el Virus de Epstein-Barr, citomegalovirus, leishmania o parvovirus B19.
Tratamiento
El diagnostico y tratamiento precoz es esencial y el tratamiento incluye varios especialistas como pediatras, hematólogos y oncólogos. Las opciones de tratamiento óptimo se determinan por varios factores, incluyendo la severidad de la enfermedad, la edad de inicio, la existencia de otros casos en la familia y las condiciones correspondientes.
El objetivo del tratamiento es suprimir la inflamación e inducir la remisión. La remisión completa se refiere a la desaparición de los signos y síntomas de la enfermedad. En algunos pacientes la linfohistiocitosis hemofagocitica se repite y el tratamiento adicional puede ser requerido.
La Sociedad de Histiocitos ha desarrollado una guía de tratamiento llamado HLH-2004 para linfohistiocitosis hemofagocitica familiar y adquirida severa, persistente o recurrente, que contempla la utilización de quimioterapia en una fase inicial de 8 semanas, seguida de una fase de mantenimiento hasta que pueda realizarse trasplante de medula ósea.
Los medicamentos utilizados incluyen etoposido con dexametasona y ciclosporina. Su médico puede presentar una solicitud en línea para la Sociedad de Histiocitosis de una copia de la guía a través de su formulario en línea. El sitio de la Sociedad lo puedes encontrar haciendo clic aquí. El protocolo de tratamiento representa la consolidación de varias formas de tratamiento con el objetivo de encontrar estabilidad clínica y posteriormente la cura con el trasplante de medula ósea.